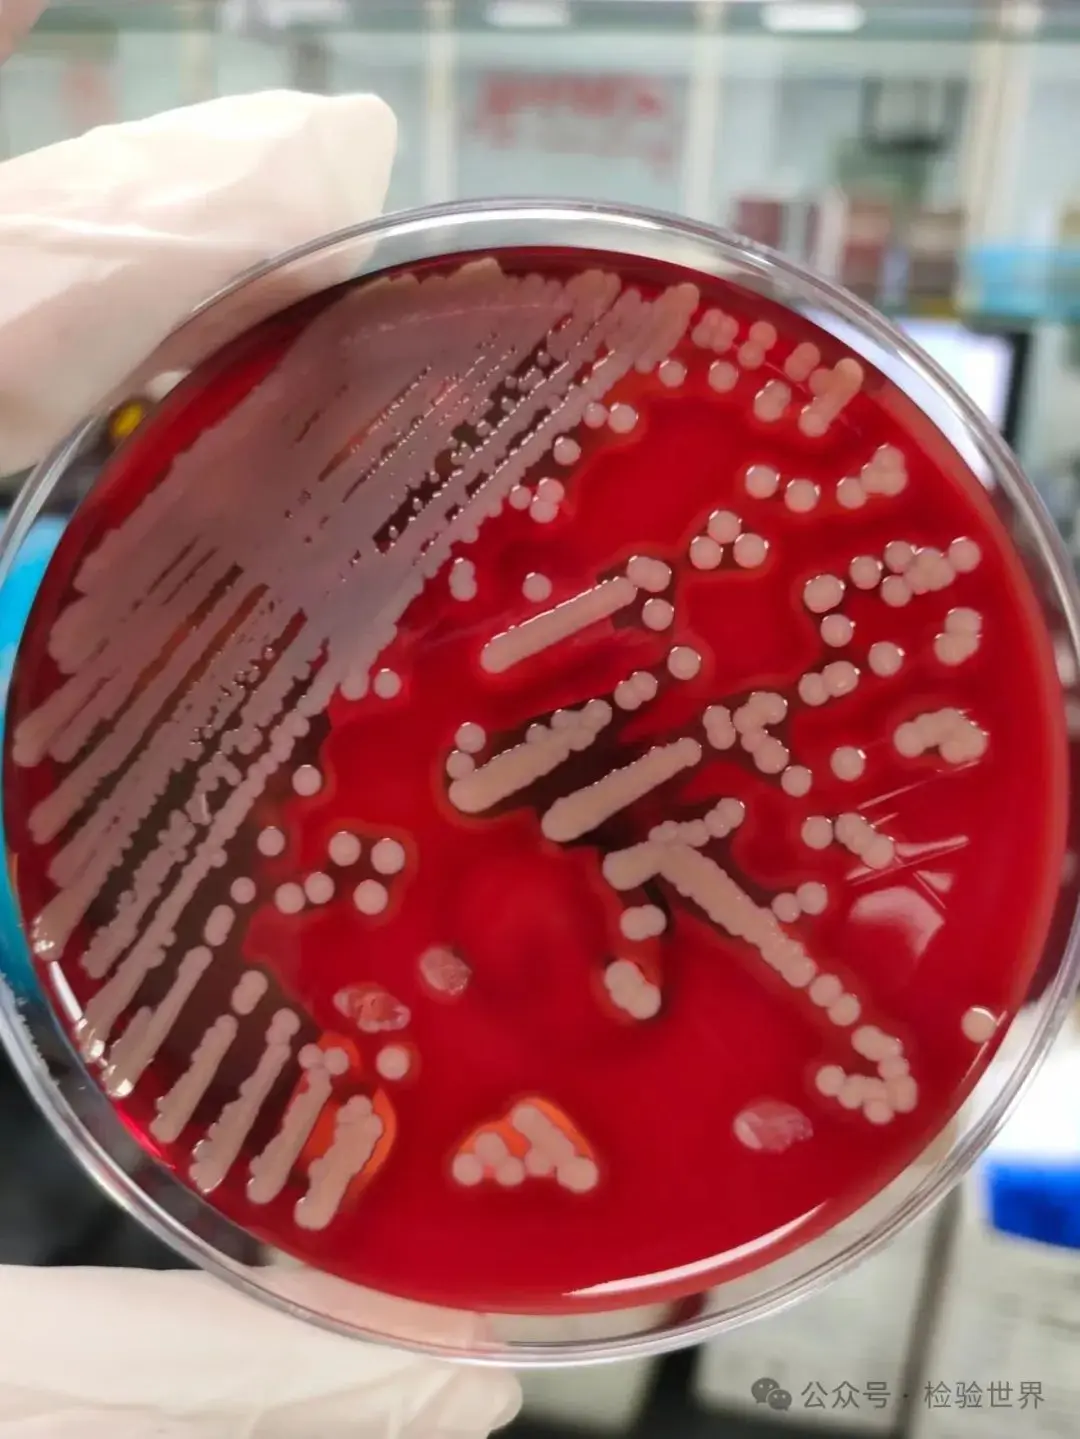
金黄色葡萄球菌菌落形态（在血琼脂平板上周围会形成透明的溶血环）

【科普一下】最可怕且最常见的菌——金黄色葡萄球菌
发布时间:2024-12-18 浏览次数:15681
金黄色葡萄球菌(Staphylococcus aureus)是一种革兰氏阳性细菌,广泛存在于人类和动物的皮肤及黏膜表面,以及在自然界中。它能引起多种感染,包括皮肤和软组织感染、骨髓炎、肺炎、败血症等。金黄色葡萄球菌是一种革兰氏阳性球菌,能够在多种环境中生存,包括医院环境。它可以通过直接接触或通过被污染的物品传播。
菌体形态
金黄色葡萄球菌是革兰氏阳性球菌,单个细胞直径大约为0.5-1.5微米,通常成单、双、短链或不规则葡萄串状排列。它们具有较厚的细胞壁,这使得它们对抗生素有较强的抵抗力。

菌落形态
在固体培养基上,金黄色葡萄球菌形成的菌落通常是圆形、表面光滑、凸起、湿润,直径约为1-3毫米。菌落颜色可以是奶油样、瓷白、浅黄色至橙黄色,在血琼脂平板上周围会形成透明的溶血环,这是由于其产生的凝固酶。
生物学性状
金黄色葡萄球菌是一种需氧或兼性厌氧菌,最适宜生长温度为37°C,最适生长pH为7.4。它具有较高的耐盐性,可以在含有10-15%NaCl的环境中生长。该菌无芽孢和鞭毛,大多数无荚膜。
理化特性
金黄色葡萄球菌能够在普通培养基上良好生长,它能够发酵葡萄糖、麦芽糖、乳糖和蔗糖,产酸不产气。该菌对某些抗生素如青霉素、红霉素等高度敏感,但对磺胺类药物的敏感性较低。此外,金黄色葡萄球菌具有较强的抵抗力,能够在不利环境中存活数周。

致病机理
金黄色葡萄球菌通过分泌多种毒素和酶来致病,包括但不限于金黄色葡萄球菌肠毒素、凝固酶、杀白细胞素等。这些毒素和酶能够破坏宿主细胞的结构和功能,引发炎症反应和组织损伤。此外,MRSA(耐甲氧西林金黄色葡萄球菌)株通过产生额外的药物抗性机制,如mecA基因编码的β-内酰胺酶,使得常规抗生素治疗变得更加困难。
相关研究
一、在不同环境条件下,金黄色葡萄球菌的生长特性有何差异?
1、温度:金黄色葡萄球菌在不同的温度条件下表现出不同的生长速率和生物膜形成能力。例如,在25℃时,细菌膜的表面积有显著性差异。此外,提高培养液的酸碱度可以缩短金黄色葡萄球菌生长曲线对数期,表明pH值的提高有助于其在特定条件下的生长。
2、盐浓度:金黄色葡萄球菌显示出对盐浓度的适应性,能够在低盐和高盐条件下生长,但随着NaCl浓度的升高,菌落形成单位(CFU)数量逐渐减少。这表明高盐环境可能抑制其生长。
3、酸碱度:金黄色葡萄球菌在不同pH值条件下生长的表现也有所不同。例如,在pH 8.4时,其生长曲线对数期更平稳。这说明酸碱度是影响其生长的一个重要因素。
4、水分活度:金黄色葡萄球菌在不同的水分活度环境下生长情况也有所差异。例如,在蔗糖介质调节水分活度为0.86时,菌落数基本维持不变,而在甘油与氯化钠调节的水分活度环境下,菌落数呈下降趋势。
5、与其他微生物的竞争:金黄色葡萄球菌在与其他微生物如大肠埃希菌混合培养时,其生长量显著降低,表明其具有一定的表型可塑性,能够根据环境变化调整自身的生理特征以应对竞争压力。
6、冷冻条件:金黄色葡萄球菌在冷冻条件下可以被诱导进入活的非可培养状态(VBNC),这种状态下虽然细胞仍具有代谢活性,但难以通过常规培养方法检测。然而,这些VBNC细胞在一定条件下可以复苏并恢复部分生理功能。
二、金黄色葡萄球菌的耐药性机制是什么?
1、β-内酰胺酶的产生:金黄色葡萄球菌能够产生β-内酰胺酶,这种酶可以水解青霉素类药物,导致对青霉素类药物的耐药性。这种耐药性的表达与mecA基因的表达有关,该基因在MRSA中的携带率高达100% 。

2、耐药基因的表达:金黄色葡萄球菌中存在多种耐药基因,如ermA、ermB、ermC等红霉素核糖体甲基化酶基因,以及aac(6′)/aph(2″)、ant(4′4″)等氨基糖苷类修饰酶基因。这些基因可以改变抗生素的作用靶位或增强细菌的外排能力,从而导致对多种抗生素的耐药 。
3、主动外排系统:金黄色葡萄球菌通过增强主动外排系统来排出进入细胞内的抗生素,这包括但不限于qacA基因所编码的外排泵 。
4、基因突变:某些抗生素的耐药性也与特定基因的突变有关,例如gyrA和grlA基因的突变会导致对氟喹诺酮类药物的耐药 。
5、诱导型耐药:克林霉素诱导型耐药是金黄色葡萄球菌的一种耐药机制,这种耐药性可以通过诱导型克林霉素耐药基因的表达来实现 。
然而,随着万古霉素的广泛应用,一些金黄色葡萄球菌已经发展出耐药性。例如,耐甲氧西林金黄色葡萄球菌(MRSA)就是一种对传统糖肽类抗生素(包括万古霉素)具有高度耐药性的菌株。这种耐药性的出现主要是由于基因突变导致的关键蛋白功能改变,如rpo B和gra S基因的突变。
预防及治疗
预防金黄色葡萄球菌感染的关键在于保持良好的个人卫生习惯,如勤洗手,以及在医院等高风险环境中采取严格的感染控制措施。对于已经发生的感染,选择合适的抗生素至关重要。万古霉素是治疗MRSA感染的首选药物,但鉴于MRSA对多种抗菌药物的耐药性日益增加,临床上需要根据药敏试验结果选择最有效的抗菌药物。此外,对于食源性金黄色葡萄球菌感染,改善食品安全管理和加强食品加工过程中的卫生控制也是预防的重要措施。

总之,金黄色葡萄球菌是一种重要的条件致病菌,其耐药性和致病机制的研究对于控制和治疗相关感染具有重要意义。通过综合应用抗菌药物、提高公共卫生水平和加强食品安全管理,可以有效减少金黄色葡萄球菌引起的健康威胁。
文章来源:环凯(官网:huankai.com)转载于“ 检验世界”公众号;原作者~脚丫。
转载声明:本文为转载发布,仅为分享学习目的。对转载有异议和删稿要求的原著方,可联络站点客服删除。
